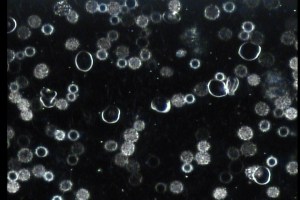
Blood 1 April29 2015
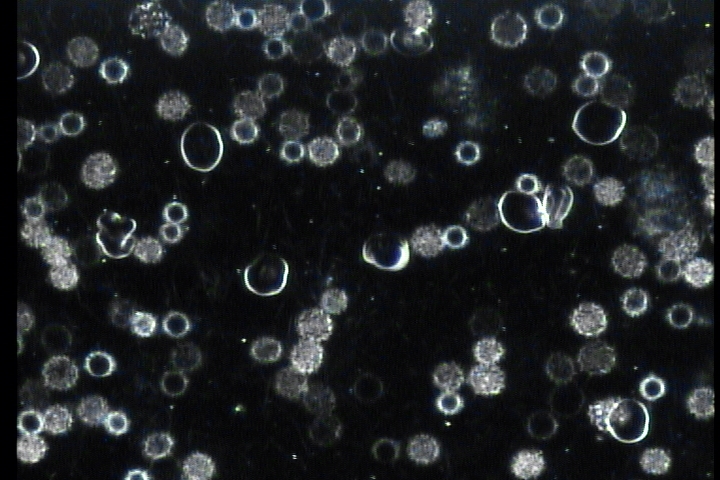

Nik’s Chicks is a FREE ladies only running/triathlon group. It is only a time and place to meet & a program to follow. I cannot join you on every run/workout. If you are new to exercising, it is advisable to have a doctor’s OK prior to beginning. Any information or products represented on this site are for educational purposes only and are not a substitute for any advice given to you by a medical, nutritional or fitness professional. Please sign my waiver (in “About”) and fill out my contact info sheet when you arrive for your first run. Please park on West Oak Trails Blvd, Nightingale or at Bloomfield Park to avoid congestion, locking beeps and car doors closing around my neighbours’ houses – especially on Saturday mornings! We run Tuesday and Thursday evenings 8pm and Saturday mornings 8am from the corner of Redwing and Blackbird Courts. Check out Weekly Workout section for specific times and distances.
Quotes of the Week:
In general, any form of exercise, if pursued continuously, will help train us in perseverance. Long-distance running is particularly good training in perseverance.
Mao Tse-Tung
A lot of people say they love running because of how they feel afterward. Not me. Well, I love that too, but it’s also so much fun while I’m out there.
Dick Beardsley
Being a runner means you are now “free” to win and lose and live life to its fullest.
Bill Rodgers
Growth and comfort seldom ride the same horse.
Unknown
News from the “Nest”: As we head into the long weekend, don’t forget to try to get your runs in so you feel less sluggish after! We tend to ingest a few extras (food and drink) during the break and then in hindsight wish we were more disciplined:) Go into the weekend with a plan and try to stick with it.
I will be away on Thursday and Saturday, but the veteran ladies will still be out! Check the Weeks Workouts section below to see what you should be doing.
NEW Programs Begin on September 13th: I will be starting new Learn to Run 5km and 10km Programs on Sunday, September 13th at 8am. (I have a triathlon race on Saturday and have moved the run to Sunday for this day only.) Remember that the programs are FREE and you are not required to attend all three sessions per week. Just do the missed sessions on your own. Please pass the word onto your girlfriends and/or daughters. I will get you to fill out a Waiver Nicole McLaughlin Waiver and Release before you begin with us and you can fill in an Emergency Contact form when you arrive for your first run. Here are the programs you will be using: Learn to Run 5km Training Program (T,Th,S) and 10 Km program from 5km base (T,Th,S) Hope we get a good turnout of returnees and newbies!
Live Blood Cell Microscopy: I had a return visit to Shannon Gregory at Balance Point Health Centre last week. My initial visit was April 29. I was feeling physically sluggish and mentally slow. She took a quick finger tip blood sample and the looked at it through a microscope while I watch it on a computer monitor. Initially she found lot of stuff that I could work on (thyroid, liver stress, parasites, protein leakage into blood, yeast, gallbladder). Sounds like I was a basket case but apparently most people have a bunch of stuff going on! Here are the before pics:
The red blood cells are stuck together, the ones with jagged borders and fuzzy insides are dead from parasites, the dashes show liver issues, blue spots are thyroid issues. (That’s all I can remember:)
I took this info to my naturopath, Dr. Jane Goehner and she developed a plan to get my systems cleaned up. Four months later I have more energy, am less forgetful and generally feel better.
Note how clear and round the blood cells are in the second two pics. I can highly recommend these two practitioners and feel like they have helped me a lot. You can book an appt with them at 289 291 0254.
Half Marathon and 10km Races?: I have registered for the Angus Glen 1/2 Marathon on November 8th! I think Lisa, Danielle, Jo, Annabel and Daisy might join me – hopefully there will be more. Here is a modified training program: Modified Angus Glen Half 2015 Please join me for the training so we can have some fun commiserating:) Register at Angus Glen 1/2
If a half is too long for you, consider doing the 10km which is on the same date. Here is your program 10 Km program from 5km base (T,Th,S) which will begin on September 13th. There are a few maybes out there – Janice, Ellen, Carol…
Triathlon: I have also registered for the Lakeside Sprint Triathlon September 12th. Any takers?! http://www.multisportcanada.com/lakeside/ I can take two extra in my van including their bikes. Lorraine is also reg, and Jo and Jaz are maybes.
Jackets and Tri tops: I only have 1 jacket remaining and half the tri tops have been picked up. You can pick them up from me when you are out for your next run. If you have seen the tops and wish you ordered one, you are in luck! I ordered a few extras. Come see me to try one on. They are 70.00 each.
Oakville 5km: Some of the 5km ladies have recently signed up for the Nutrience 5km here in Oakville on September 23. You can sign up for this race at Oakville 5m
Have you Ordered Your Road ID?: Spend the 20.00 on some peace of mind NOW! If you were unconscious during a run, would EMS personnel know your details? Unlikely!! Order a bracelet or shoe tag at Road ID
Tips From Runner’s World Daily Calendar 2015: 1) Though shoe companies put huge resources into quality control, no two shoes are exactly the same. The same shoe can be made in different factories with different levels of quality control. Always try on the shoes 2) Runner’s toe is frequently caused by not keeping toenails closely clipped. If the end of the toenail jams into the shoe, the base of the nail wiggles enough to cause bleeding just below the surface. Also consider going up a 1/2 size in your shoes. 3 ) Overpronators frequently find calluses on the inside of their big toes or at the ends of their toes. Severe over pronators are susceptible to Achilles tendinitis, runner’s knee and shin splints. 4) When you start running, it’s common to tense up a lot of the upper body muscles that aren’t involved in running, which can sap the strength that your lungs and legs need. When running starts to feel difficult, do a “body scan”. Unfurl your brow, unclench your jaw, bring your shoulders down away from your ears, and keep your hands loose. Avoid clenching your fists. Imagine you are holding a piece of paper between each thumb and forefinger. 5) It’s physiologically impossible for your body to maintain the same pace in a hot temperature as you do in a cool. Don’t worry, that’s perfectly normal.
This week’s workouts (Meet at 1438 Redwing Court):
(NEW 5km and 10km programs begin on Sept 13th)
Tuesday – September 1 8:00pm
Holding on 5km – 5-6km
Holding on 10 km – 5-6km
Half Marathon – Oakville/Scotiabank/Angus Glen 10km
Thursday – September 3 8:00pm
Holding on 5km – 6km with 45 sec sprints x 6 repeats
Holding on 10 km – 6km with 45 sec sprints x 6 repeats
Half Marathon – (Supposed to be hill but switching to Sprints!) 6km with 45 sec sprints x 6 repeats
Kelso Open Water Swimming – Last Tursday session 6:30pm
Saturday – September 5 8:00am
Holding on 5km – 5km
Holding on 10 km – 10km
Half Marathon – Oakville = 15km, Scotiabank 11, and Angus Glen 10km
Kelso Open Water Swimming – Last Saturday session 8:15am
Holiday Monday – September 7 8:00am
Half Marathoners: Oakville = 21km, Scotiabank = 17km, Angus Glen = 13km (You get to skip Tuesday night run!)
Tuesday – September 8 8:00pm
Holding on 5km – 5-6km
Holding on 10 km – 5-6km
Half Marathon – rest
Thursday – September 10 8:00pm
Holding on 5km – 6km with 45 sec sprints x 6 repeats
Holding on 10 km – 6km with 45 sec sprints x 6 repeats
Half Marathon – (Supposed to be hill but switching to Sprints!) 6km with 45 sec sprints x 6 repeats
Kelso Open Water Swimming – Last Thursday session 6:30pm
Saturday – September 12 8:00am RUNS MOVED TO TOMORROW FOR THIS WEEK ONLY
Kelso Open Water Swimming – Last Saturday session 8:30am
Sunday – September 13th 8:00am NEW PROGRAMS BEGIN
Learn to Run 5km – 5 min warm up walk, alternate 60 sec jogging and 90 sec walking for 20 minutes (turn after 10min), 5 min cool down walk, stretch
Holding on 5km – 5km
Learn to Run 10km – 5km
Holding on 10km – 10km
Half Marathon – Oakville = 15km, Scotiabank = 19km, Angus Glen = 15km
Have a wonderful week! Niki